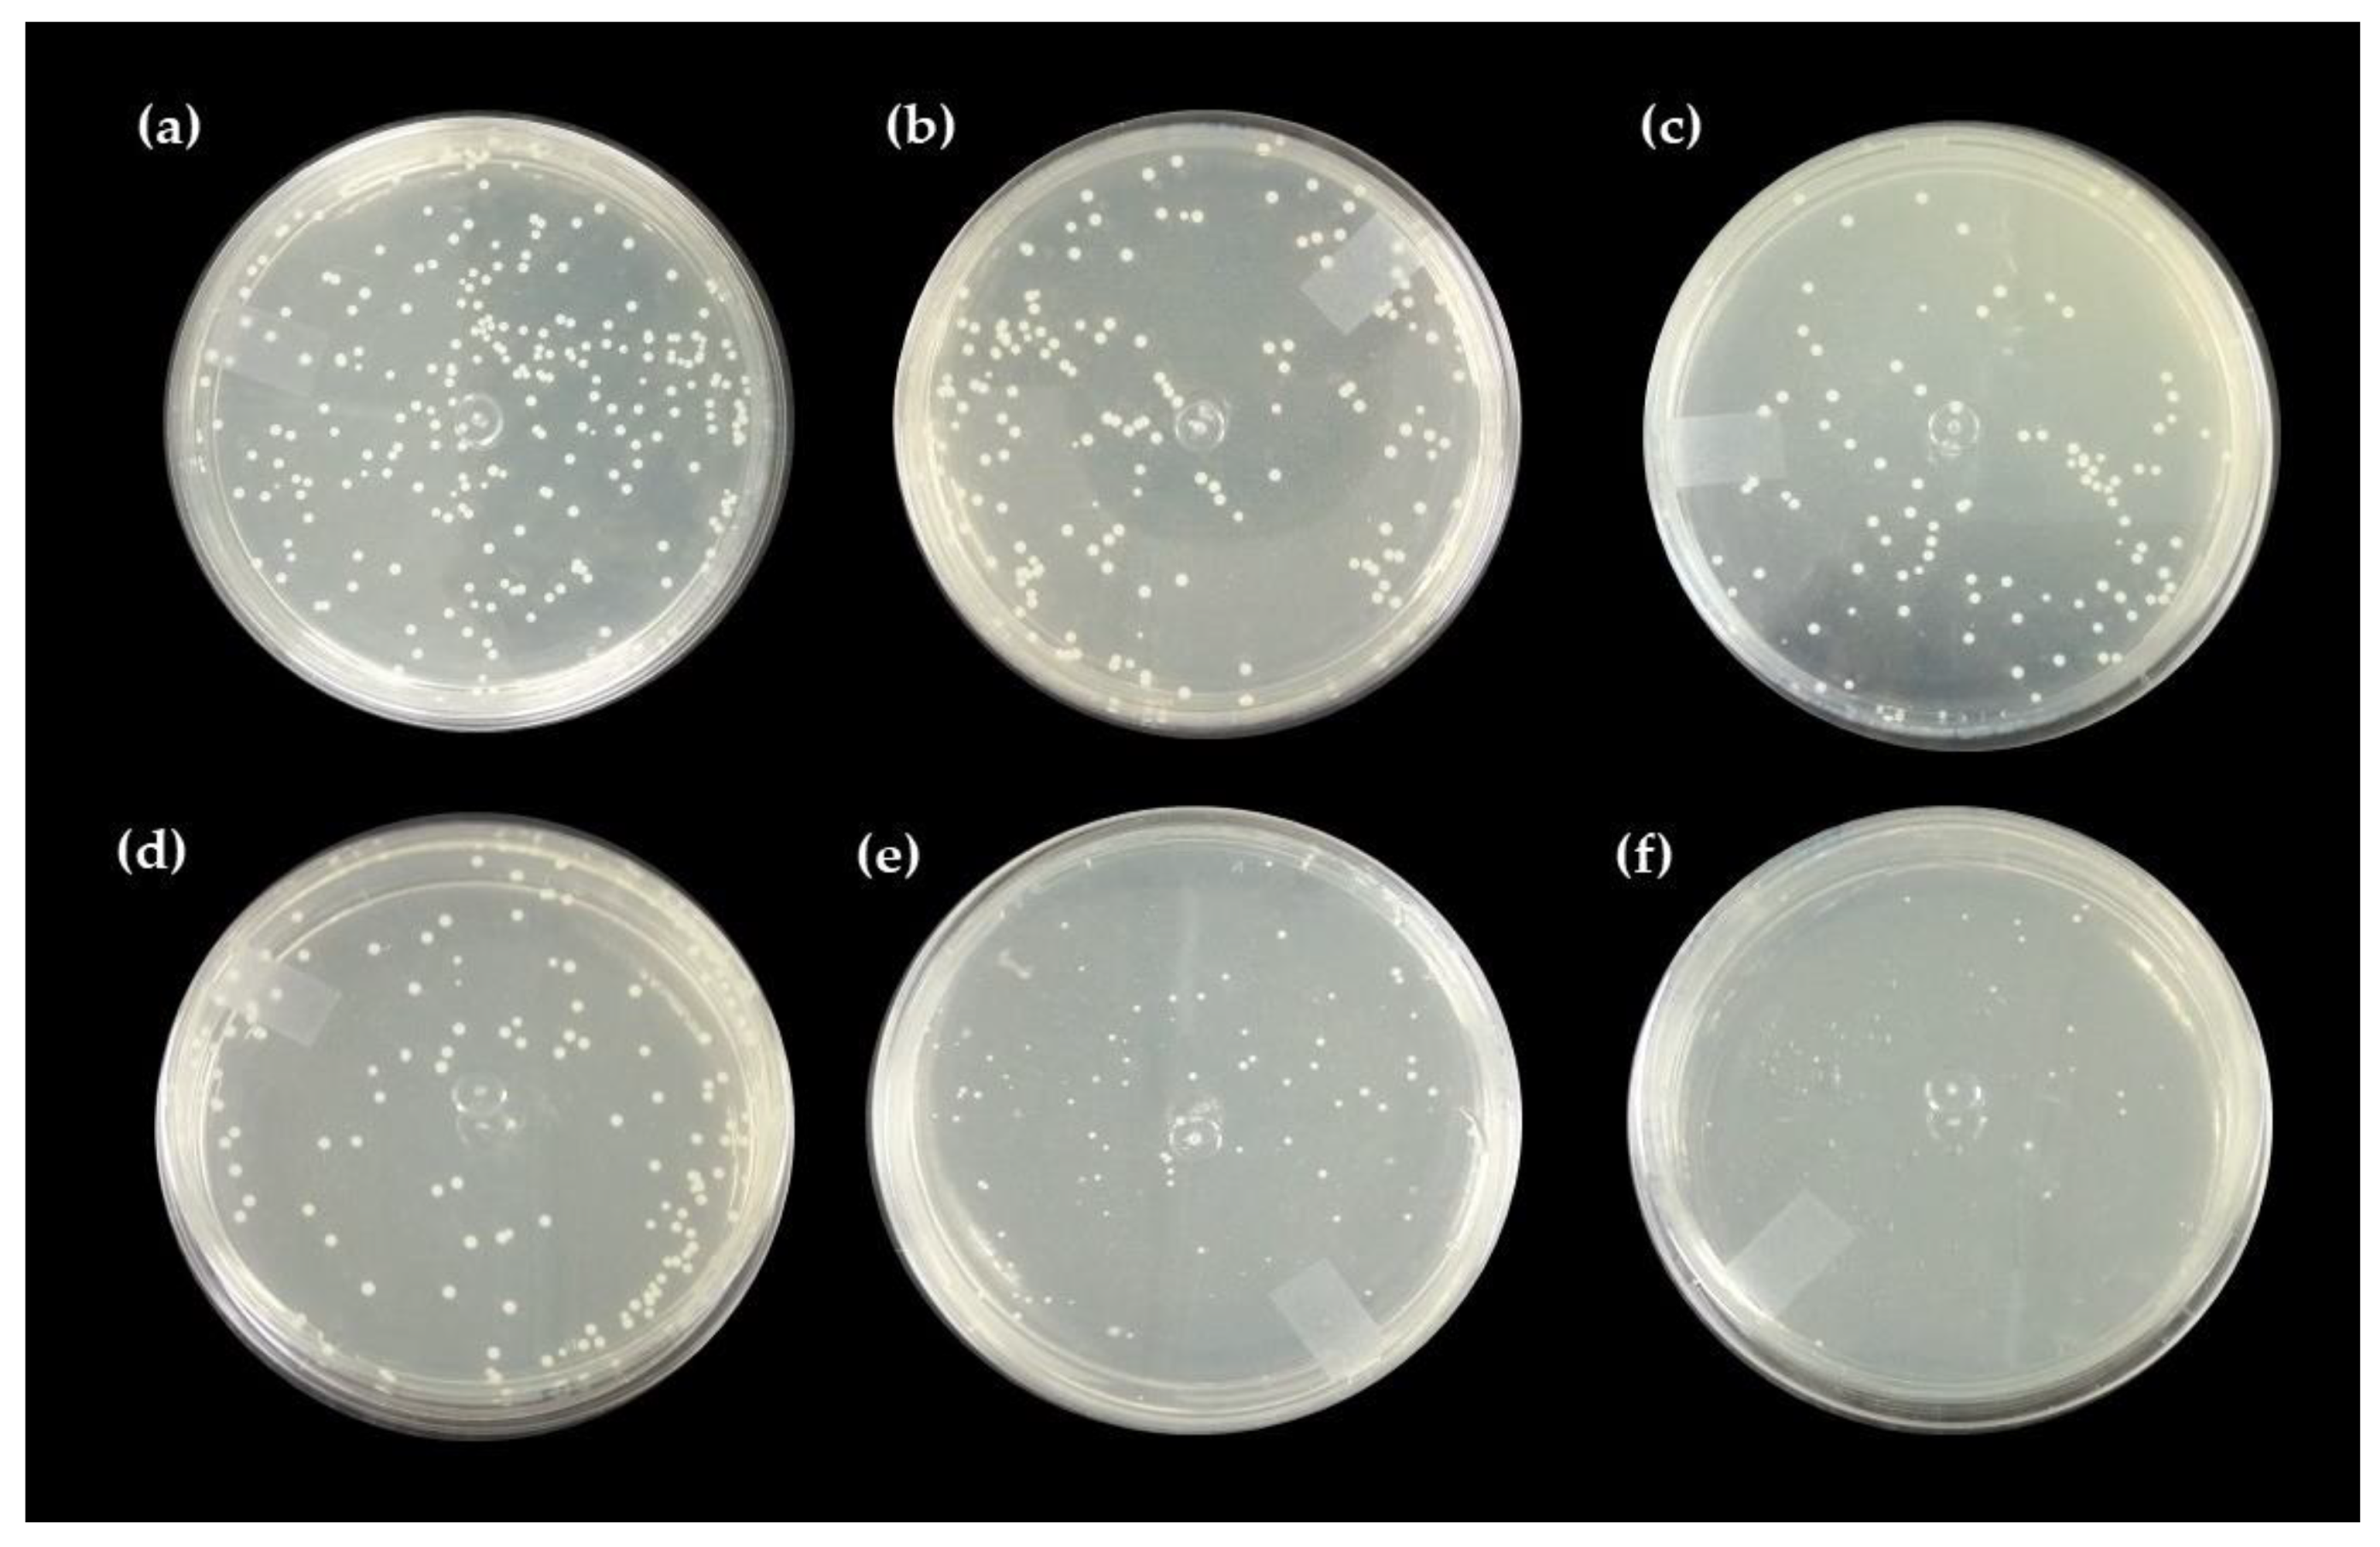
Ijms 24 02210 g005 Ijms 24 02210 g005
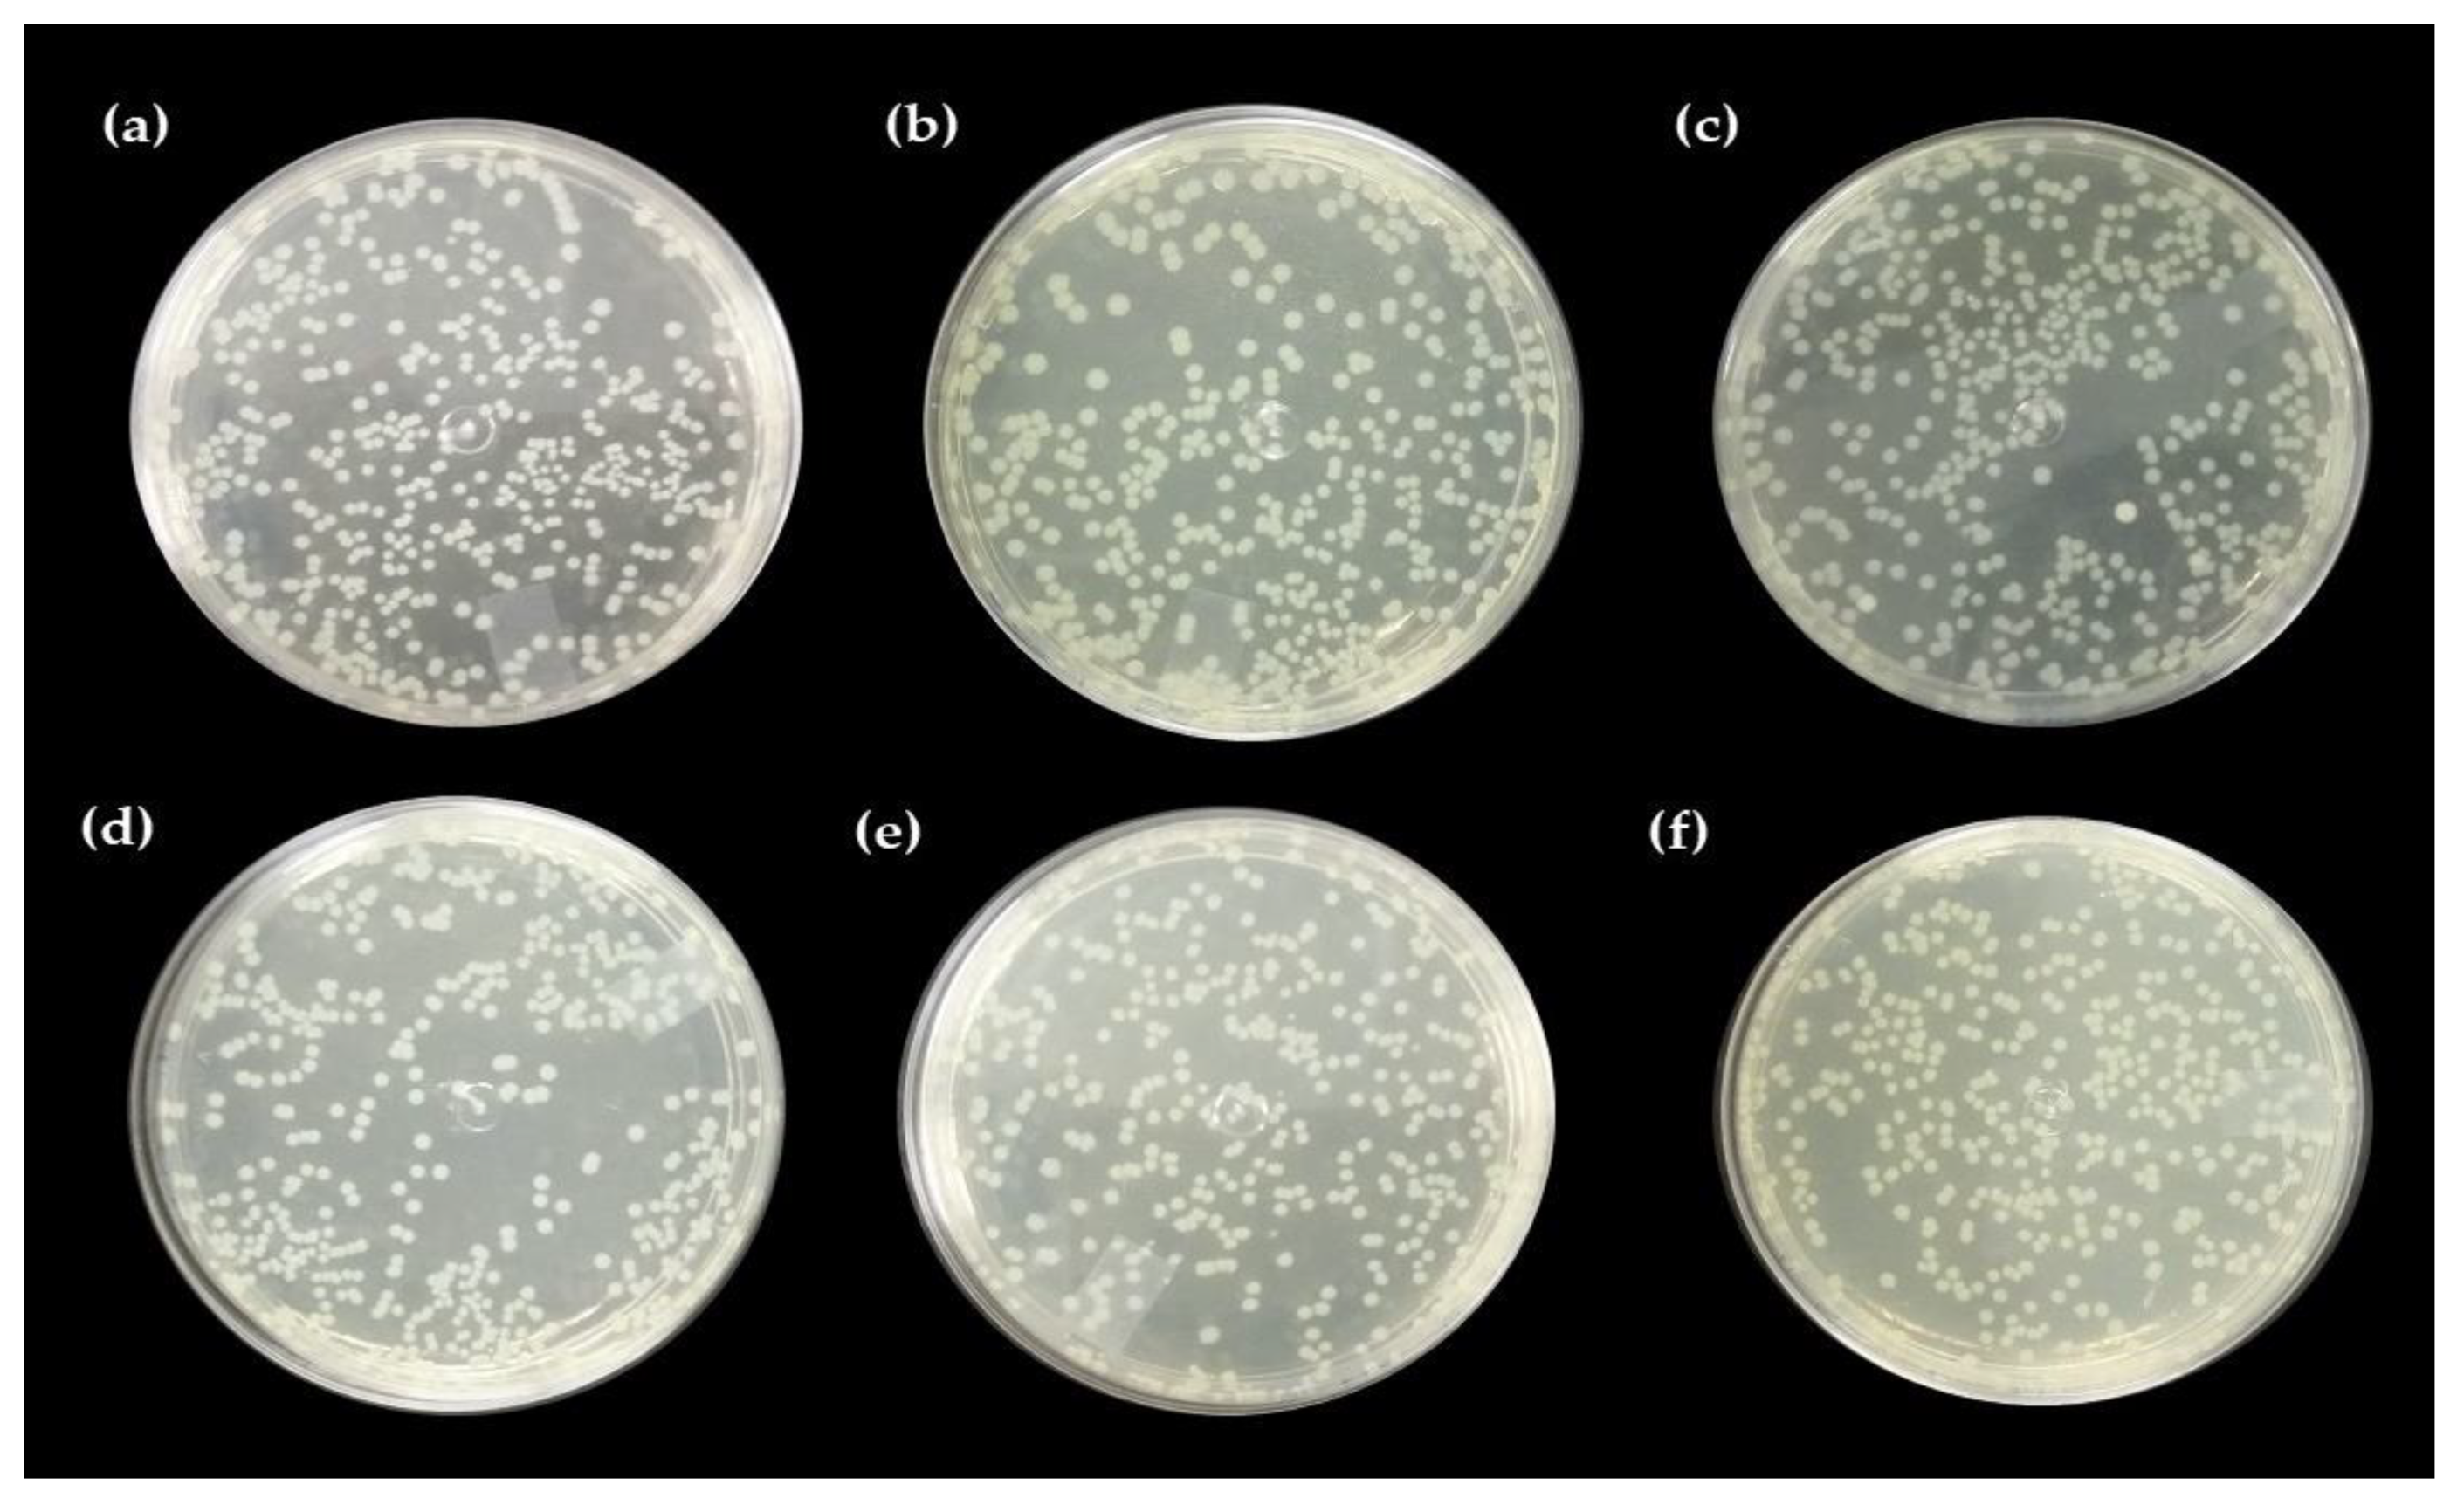
Ijms 24 02210 g006 Ijms 24 02210 g006

Antibacterial and Healing Effect of Chicha Gum Hydrogel (Sterculia striata) with Nerolidol
Abstract
1. Introduction
2. Results and Discussion
2.1. Thermal Analysis
2.2. Spectroscopy in the Infrared Region
2.3. Mechanical Properties
2.4. Toxicity to Artemia salina
2.5. Antibacterial Activity
Direct Contact Test with the Pure Hydrogel and Associated with Nerolidol
2.6. Healing Test
2.7. Macroscopic Analysis of the Wound
Qualitative Histological Analysis
3. Materials and Methods
3.1. Materials
3.2. Isolation and Purification of Chicha Gum
3.3. Synthesis of Hydrogels
Chicha Hydrogel with 0.01 e 0.02 g mL−1 Nerolidol
3.4. Characterizations
3.5. Cytoxicity Test against Artemia salina
3.5.1. Synthetic Seawater Preparation
3.5.2. Toxicity Test
3.6. Antimicrobial Test
3.6.1. Bacterial Lineage
3.6.2. Inoculum Preparation
3.6.3. Antibacterial Activity by Direct Contact Method
3.7. Healing Test
3.7.1. Ethical Aspects
3.7.2. Animals
3.7.3. Experimental Design
3.7.4. Surgical Procedure
3.7.5. Wound Care
3.7.6. Euthanasia of Animals
3.7.7. Macroscopic Evaluation of the Skin Lesion
3.7.8. Qualitative Histological Evaluation of the Skin Lesion
4. Conclusions
Author Contributions
Funding
Institutional Review Board Statement
Informed Consent Statement
Data Availability Statement
Acknowledgments
Conflicts of Interest
References
- Brito, A.C.F.; Silva, D.A.; de Paula, R.C.M.; Feitosa, J.P.A. Sterculia Striata Exudate Polysaccharide: Characterization, Rheological Properties and Comparison with Sterculia Urens (Karaya) Polysaccharide. Polym. Int. 2004, 53, 1025–1032. [Google Scholar] [CrossRef]
- Rahal, S.C.; Rocha, N.S.; Blessa, É.P.; Iwabe, S.; Crocci, A.J. Pomada Orgânica Natural Ou Solução Salina Isotônica No Tratamento de Feridas Limpas Induzidas Em Ratos. Ciência Rural 2001, 31, 1007–1011. [Google Scholar] [CrossRef]
- Freitas, A.A.R.; Ribeiro, A.J.; Santos, A.C.; Veiga, F.; Nunes, L.C.C.; Silva, D.A.; Soares-Sobrinho, J.L.; Silva-Filho, E.C. Sterculia Striata Gum as a Potential Oral Delivery System for Protein Drugs. Int. J. Biol. Macromol. 2020, 164, 1683–1692. [Google Scholar] [CrossRef] [PubMed]
- Sombra, F.M.; Richter, A.R.; de Araújo, A.R.; de Oliveira Silva Ribeiro, F.; de Souza Mendes, J.F.; dos Santos Fontenelle, R.O.; da Silva, D.A.; Paula, H.C.B.; Feitosa, J.P.A.; Goycoolea, F.M.; et al. Development of Amphotericin B-Loaded Propionate Sterculia Striata Polysaccharide Nanocarrier. Int. J. Biol. Macromol. 2020, 146, 1133–1141. [Google Scholar] [CrossRef] [PubMed]
- Ferreira, M.O.G.; de Lima, I.S.; Morais, A.Í.S.; Silva, S.O.; de Carvalho, R.B.F.; Ribeiro, A.B.; Osajima, J.A.; Silva Filho, E.C. Chitosan Associated with Chlorhexidine in Gel Form: Synthesis, Characterization and Healing Wounds Applications. J. Drug Deliv. Sci. Technol. 2019, 49, 375–382. [Google Scholar] [CrossRef]
- Kaewpirom, S.; Boonsang, S. Electrical Response Characterisation of Poly(Ethylene Glycol) Macromer (PEGM)/Chitosan Hydrogels in NaCl Solution. Eur. Polym. J. 2006, 42, 1609–1616. [Google Scholar] [CrossRef]
- Teng, D.Y.; Wu, Z.M.; Zhang, X.G.; Wang, Y.X.; Zheng, C.; Wang, Z.; Li, C.X. Synthesis and Characterization of in Situ Cross-Linked Hydrogel Based on Self-Assembly of Thiol-Modified Chitosan with PEG Diacrylate Using Michael Type Addition. Polymer 2010, 51, 639–646. [Google Scholar] [CrossRef]
- De Pereira, V.A.; Ribeiro, I.S.; Paula, H.C.B.; de Paula, R.C.M.; Sommer, R.L.; Rodriguez, R.J.S.; Abreu, F.O.M.S. Chitosan-Based Hydrogel for Magnetic Particle Coating. React. Funct. Polym. 2020, 146, 104431. [Google Scholar] [CrossRef]
- Ma, L.; Zou, L.; McClements, D.J.; Liu, W. One-Step Preparation of High Internal Phase Emulsions Using Natural Edible Pickering Stabilizers: Gliadin Nanoparticles/Gum Arabic. Food Hydrocoll. 2020, 100, 105381. [Google Scholar] [CrossRef]
- Quesada, H.B.; De Araújo, T.P.; Cusioli, L.F.; De Barros, M.A.S.D.; Gomes, R.G.; Bergamasco, R. Evaluation of Novel Activated Carbons from Chichá-Do-Cerrado (Sterculia Striata St. Hil. et Naud) Fruit Shells on Metformin Adsorption and Treatment of a Synthetic Mixture. J. Environ. Chem. Eng. 2021, 9, 104914. [Google Scholar] [CrossRef]
- Magalhães, G.A.; Moura Neto, E.; Sombra, V.G.; Richter, A.R.; Abreu, C.M.W.S.; Feitosa, J.P.A.; Paula, H.C.B.; Goycoolea, F.M.; de Paula, R.C.M. Chitosan/Sterculia Striata Polysaccharides Nanocomplex as a Potential Chloroquine Drug Release Device. Int. J. Biol. Macromol. 2016, 88, 244–253. [Google Scholar] [CrossRef] [PubMed]
- Silva, S.C.C.C.; de Araujo Braz, E.M.; de Amorim Carvalho, F.A.; de Sousa Brito, C.A.R.; Brito, L.M.; Barreto, H.M.; da Silva Filho, E.C.; da Silva, D.A. Antibacterial and Cytotoxic Properties from Esterified Sterculia Gum. Int. J. Biol. Macromol. 2020, 164, 606–615. [Google Scholar] [CrossRef] [PubMed]
- Paula, H.C.B.; Oliveira, E.F.; Carneiro, M.J.M.; De Paula, R.C.M. Matrix Effect on the Spray Drying Nanoencapsulation of Lippia Sidoides Essential Oil in Chitosan-Native Gum Blends. Planta Med. 2017, 83, 392–397. [Google Scholar] [CrossRef] [PubMed]
- Bakkali, F.; Averbeck, S.; Averbeck, D.; Idaomar, M. Biological Effects of Essential Oils–A Review. Food Chem. Toxicol. 2008, 46, 446–475. [Google Scholar] [CrossRef]
- Burt, S. Essential Oils: Their Antibacterial Properties and Potential Applications in Foods-A Review. Int. J. Food Microbiol. 2004, 94, 223–253. [Google Scholar] [CrossRef]
- Baldissera, M.D.; Souza, C.F.; da Silva, A.S.; Velho, M.C.; Ourique, A.F.; Baldisserotto, B. Benefits of Nanotechnology: Dietary Supplementation with Nerolidol-Loaded Nanospheres Increases Survival Rates, Reduces Bacterial Loads and Prevents Oxidative Damage in Brains of Nile Tilapia Experimentally Infected by Streptococcus Agalactiae. Microb. Pathog. 2020, 141, 103989. [Google Scholar] [CrossRef]
- Berger, J.; Reist, M.; Mayer, J.M.; Felt, O.; Peppas, N.A.; Gurny, R. Structure and Interactions in Covalently and Ionically Crosslinked Chitosan Hydrogels for Biomedical Applications. Eur. J. Pharm. Biopharm. 2004, 57, 19–34. [Google Scholar] [CrossRef]
- Curvelo, J.A.R.; Marques, A.M.; Barreto, A.L.S.; Romanos, M.T.V.; Portela, M.B.; Kaplan, M.A.C.; Soares, R.M.A. A Novel Nerolidol-Rich Essential Oil from Piper Claussenianum Modulates Candida Albicans Biofilm. J. Med. Microbiol. 2014, 63, 697–702. [Google Scholar] [CrossRef]
- Iqubal, A.; Syed, M.A.; Najmi, A.K.; Azam, F.; Barreto, G.E.; Iqubal, M.K.; Ali, J.; Haque, S.E. Nano-Engineered Nerolidol Loaded Lipid Carrier Delivery System Attenuates Cyclophosphamide Neurotoxicity–Probable Role of NLRP3 Inflammasome and Caspase-1. Exp. Neurol. 2020, 334, 113464. [Google Scholar] [CrossRef]
- Pacifico, S.; D’Abrosca, B.; Golino, A.; Mastellone, C.; Piccolella, S.; Fiorentino, A.; Monaco, P. Antioxidant Evaluation of Polyhydroxylated Nerolidols from Redroot Pigweed (Amaranthus Retroflexus) Leaves. LWT-Food Sci. Technol. 2008, 41, 1665–1671. [Google Scholar] [CrossRef]
- Koudou, J.; Abena, A.A.; Ngaissona, P.; Bessière, J.M. Chemical Composition and Pharmacological Activity of Essential Oil of Canarium Schweinfurthii. Fitoterapia 2005, 76, 700–703. [Google Scholar] [CrossRef] [PubMed]
- Harada, K.; Asai, T. Role of Antimicrobial Selective Pressure and Secondary Factors on Antimicrobial Resistance Prevalence in Escherichia Coli from Food-Producing Animals in Japan. J. Biomed. Biotechnol. 2010, 2010, 180682. [Google Scholar] [CrossRef] [PubMed]
- Pourakbari, B.; Mamishi, S.; Mashoori, N.; Mahboobi, N.; Ashtiani, M.H.; Afsharpaiman, S.; Abedini, M. Frequency and Antimicrobial Susceptibility of Shigella Species Isolated in Children Medical Center Hospital, Tehran, Iran, 2001–2006. Brazilian J. Infect. Dis. 2010, 14, 153–157. [Google Scholar] [CrossRef]
- Da Silva, P.T.; da Cunha Xavier, J.; Freitas, T.S.; Oliveira, M.M.; Coutinho, H.D.M.; Leal, A.L.A.B.; Barreto, H.M.; Bandeira, P.N.; Nogueira, C.E.S.; Sena, D.M.; et al. Synthesis, Spectroscopic Characterization and Antibacterial Evaluation by Chalcones Derived of Acetophenone Isolated from Croton Anisodontus Müll.Arg. J. Mol. Struct. 2021, 1226, 129403. [Google Scholar] [CrossRef]
- Lenzi, R.M.; Campestrini, L.H.; Okumura, L.M.; Bertol, G.; Kaiser, S.; Ortega, G.G.; Gomes, E.M.; Bovo, F.; Zawadzki-Baggio, S.F.; Stevan-Hancke, F.R.; et al. Effects of Aqueous Fractions of Uncaria Tomentosa (Willd.) D.C. on Macrophage Modulatory Activities. Food Res. Int. 2013, 53, 767–779. [Google Scholar] [CrossRef]
- Braz, E.M.A.; Silva, S.C.C.C.; Brito, C.A.R.S.; Carvalho, F.A.A.; Alves, M.M.M.; Barreto, H.M.; Silva, D.A.; Magalhães, R.; Oliveira, A.L.; Silva-Filho, E.C. Modified Chicha Gum by Acetylation for Antimicrobial and Antiparasitic Applications: Characterization and Biological Properties. Int. J. Biol. Macromol. 2020, 160, 1177–1188. [Google Scholar] [CrossRef]
- Boributh, S.; Chanachai, A.; Jiraratananon, R. Modification of PVDF Membrane by Chitosan Solution for Reducing Protein Fouling. J. Memb. Sci. 2009, 342, 97–104. [Google Scholar] [CrossRef]
- Parvez, S.; Karole, A.; Mudavath, S.L. Fabrication, Physicochemical Characterization and In Vitro Anticancer Activity of Nerolidol Encapsulated Solid Lipid Nanoparticles in Human Colorectal Cell Line. Colloids Surfaces B Biointerfaces 2022, 215, 112520. [Google Scholar] [CrossRef]
- Leonardi, G.; Maia, C.P.M.B.G. Estabilidade de Formulações Cosméticas. Int. J. Pharm. Compound Ed Bras. 2001, 3, 154–156. [Google Scholar]
- Kamaruzaman, N.; Yusop, S.M. Determination of Stability of Cosmetic Formulations Incorporated with Water-Soluble Elastin Isolated from Poultry. J. King Saud Univ.-Sci. 2021, 33, 101519. [Google Scholar] [CrossRef]
- Lau, M.H.; Tang, J.; Paulson, A.T. Texture Profile and Turbidity of Gellan/Gelatin Mixed Gels. Food Res. Int. 2000, 33, 665–671. [Google Scholar] [CrossRef]
- Morris, E.R.; Nishinari, K.; Rinaudo, M. Gelation of Gellan-A Review. Food Hydrocoll. 2012, 28, 373–411. [Google Scholar] [CrossRef]
- Huang, M.; Kennedy, J.F.; Li, B.; Xu, X.; Xie, B.J. Characters of Rice Starch Gel Modified by Gellan, Carrageenan, and Glucomannan: A Texture Profile Analysis Study. Carbohydr. Polym. 2007, 69, 411–418. [Google Scholar] [CrossRef]
- Wei, Y.; Xie, R.; Lin, Y.; Xu, Y.; Wang, F.; Liang, W.; Zhang, J. Structure Formation in PH-Sensitive Hydrogels Composed of Sodium Caseinate and N,O-Carboxymethyl Chitosan. Int. J. Biol. Macromol. 2016, 89, 353–359. [Google Scholar] [CrossRef]
- Corrêa, N.M.; Camargo Júnior, F.B.; Ignácio, R.F.; Leonardi, G.R. Avaliação Do Comportamento Reológico de Diferentes Géis Hidrofílicos. Rev. Bras. Ciências Farm. 2005, 41, 73–78. [Google Scholar] [CrossRef]
- Meyer, B.N.; Ferrigni, N.R.; Putnam, J.E.; Jacobsen, L.B.; Nichols, D.E.; McLaughlin, J.L. Brine Shrimp: A Convenient General Bioassay for Active Plant Constituents. Planta Med. 1982, 45, 31–34. [Google Scholar] [CrossRef] [PubMed]
- McLaughlin, J.L.; Chang, C.J.; Smith, D.L.; McLaughlin, J.; Chang, C.-J.; Smith, D.; Chang, C.-C.; Smith, D. Bench Top Bioassays for the Discovery of Bioactive Natural Products: An Update. 1991. [Google Scholar]
- Ferreira, M.O.G.; Leite, L.L.R.; de Lima, I.S.; Barreto, H.M.; Nunes, L.C.C.; Ribeiro, A.B.; Osajima, J.A.; da Silva Filho, E.C. Chitosan Hydrogel in Combination with Nerolidol for Healing Wounds. Carbohydr. Polym. 2016, 152, 409–418. [Google Scholar] [CrossRef]
- Campos, D.A.; Ribeiro, A.C.; Costa, E.M.; Fernandes, J.C.; Tavaria, F.K.; Araruna, F.B.; Eiras, C.; Eaton, P.; Leite, J.R.S.A.; Manuela Pintado, M. Study of Antimicrobial Activity and Atomic Force Microscopy Imaging of the Action Mechanism of Cashew Tree Gum. Carbohydr. Polym. 2012, 90, 270–274. [Google Scholar] [CrossRef]
- Silva, S.C.C.C.; Braz, E.M.A.; Brito, C.A.R.S.; Alves, M.M.M.; Carvalho, F.A.A.; Barreto, H.M.; Oliveira, A.L.; Silva, D.A.; Silva-Filho, E.C. Phthalic Anhydride Esterified Chicha Gum: Characterization and Antibacterial Activity. Carbohydr. Polym. 2021, 251, 117077. [Google Scholar] [CrossRef]
- Brehm-Stecher, B.F.; Johnson, E.A. Sensitization of Staphylococcus Aureus and Escherichia Coli to Antibiotics by the Sesquiterpenoids Nerolidol, Farnesol, Bisabolol, and Apritone. Antimicrob. Agents Chemother. 2003, 47, 3357–3360. [Google Scholar] [CrossRef]
- Zhao, X.; Wu, H.; Guo, B.; Dong, R.; Qiu, Y.; Ma, P.X. Antibacterial Anti-Oxidant Electroactive Injectable Hydrogel as Self-Healing Wound Dressing with Hemostasis and Adhesiveness for Cutaneous Wound Healing. Biomaterials 2017, 122, 34–47. [Google Scholar] [CrossRef] [PubMed]
- Mohan, C.C.; Chennazhi, K.P.; Menon, D. In Vitro Hemocompatibility and Vascular Endothelial Cell Functionality on Titania Nanostructures under Static and Dynamic Conditions for Improved Coronary Stenting Applications. Acta Biomater. 2013, 9, 9568–9577. [Google Scholar] [CrossRef] [PubMed]
- Peplow, P.V.; Chatterjee, M.P. A Review of the Influence of Growth Factors and Cytokines in in Vitro Human Keratinocyte Migration. Cytokine 2013, 62, 1–21. [Google Scholar] [CrossRef] [PubMed]
- Duffy, C.F.; Power, R.F. Antioxidant and Antimicrobial Properties of Some Chinese Plant Extracts. Int. J. Antimicrob. Agents 2001, 17, 527–529. [Google Scholar] [CrossRef] [PubMed]
- Ostrosky, E.A.; Mizumoto, M.K.; Lima, M.E.L.; Kaneko, T.M.; Nishikawa, S.O.; Freitas, B.R. Divulgação Da Concentração Mínima Inibitória (CMI) de Plantas Medicinais. Rev. Brasileira De Farmacogn. 2008, 18, 301–307. [Google Scholar] [CrossRef]
- Aparecida Da Silva, A.; Leal-Junior, E.C.P.; Alves, A.C.A.; Rambo, C.S.; Dos Santos, S.A.; Vieira, R.P.; De Carvalho, P.D.T.C. Wound-Healing Effects of Low-Level Laser Therapy in Diabetic Rats Involve the Modulation of MMP-2 and MMP-9 and the Redistribution of Collagen Types i and III. J. Cosmet. Laser Ther. 2013, 15, 210–216. [Google Scholar] [CrossRef]
- Histing, T.; Heerschop, K.; Klein, M.; Scheuer, C.; Stenger, D.; Holstein, J.H.; Pohlemann, T.; Menger, M.D. Characterization of the Healing Process in Non-Stabilized and Stabilized Femur Fractures in Mice. Arch. Orthop. Trauma Surg. 2016, 136, 203–211. [Google Scholar] [CrossRef]
- Donato-Trancoso, A.; Monte-Alto-Costa, A.; Romana-Souza, B. Olive Oil-Induced Reduction of Oxidative Damage and Inflammation Promotes Wound Healing of Pressure Ulcers in Mice. J. Dermatol. Sci. 2016, 83, 60–69. [Google Scholar] [CrossRef]
- Emes, Y.; Aybar, B.; Vural, P.; İşsever, H.; Yalçin, S.; Atalay, B.; Dinçol, E.; Bilir, A. Effects of Hemostatic Agents on Fibroblast Cells. Implant Dent. 2014, 23, 1. [Google Scholar] [CrossRef]
- Chen, S.H.; Tsao, C.T.; Chang, C.H.; Lai, Y.T.; Wu, M.F.; Chuang, C.N.; Chou, H.C.; Wang, C.K.; Hsieh, K.H. Assessment of Reinforced Poly(Ethylene Glycol) Chitosan Hydrogels as Dressings in a Mouse Skin Wound Defect Model. Mater. Sci. Eng. C 2013, 33, 2584–2594. [Google Scholar] [CrossRef]
- Marei, N.H.; El-Mazny, W.; El-Shaer, A.; Zaki, K.D.; Hussein, Z.S.; Abd-El-Samie, E.M. Enhanced Wound Healing Activity of Desert Locust (Schistocerca Gregaria) vs. Shrimp (Penaeus Monodon) Chitosan Based Scaffolds. Int. J. Biol. Macromol. 2017, 97, 23–33. [Google Scholar] [CrossRef] [PubMed]
- Na, Y.K.; Ban, J.J.; Lee, M.; Im, W.; Kim, M. Wound Healing Potential of Adipose Tissue Stem Cell Extract. Biochem. Biophys. Res. Commun. 2017, 485, 30–34. [Google Scholar] [CrossRef]
- Du, L.; Tong, L.; Jin, Y.; Jia, J.; Liu, Y.; Su, C.; Yu, S.; Li, X. A Multifunctional in Situforming Hydrogel for Wound Healing. Wound Repair Regen. 2012, 20, 904–910. [Google Scholar] [CrossRef] [PubMed]
- Azad, A.K.; Sermsintham, N.; Chandrkrachang, S.; Stevens, W.F. Chitosan Membrane as a Wound-Healing Dressing: Characterization and Clinical Application. J. Biomed. Mater. Res. 2004, 69B, 216–222. [Google Scholar] [CrossRef] [PubMed]
- Costa, S.M.O.; Rodrigues, J.F.; de Paula, R.C.M. Monitorização Do Processo de Purificação de Gomas Naturais: Goma Do Cajueiro. Polímeros Ciência e Tecnol. 1996, 6, 4. [Google Scholar] [CrossRef]
- Zheng, L.-Y.; Zhu, J.-F. Study on Antimicrobial Activity of Chitosan with Different Molecular Weights. Carbohydr. Polym. 2003, 54, 527–530. [Google Scholar] [CrossRef]
- De Oliveira Marques Dos Santos, L.; De Lourdes Pessole Biondo Simões, M.; Bächtold Machado, A.P.; Matioski Filho, G.R.; Endo, P.C.; Gruen, G.R.; Cipriani, V.R.; Mesquita, L.D. Efeito Da Somatotropina Sobre a Cicatrização de Feridas Cutâneas, Em Ratos. Acta Cir. Bras. 2002, 17, 220–224. [Google Scholar] [CrossRef]
- Ghali, S.; Turza, K.C.; Baumann, D.P.; Butler, C.E. Minimally Invasive Component Separation Results in Fewer Wound-Healing Complications than Open Component Separation for Large Ventral Hernia Repairs. J. Am. Coll. Surg. 2012, 214, 981–989. [Google Scholar] [CrossRef]

| Sample | Area 1 [g s] (Cohesion) | Area 2 [g s] (Adhesiveness) | Force 1 [g] (Maximum Compression Force) | Force 2 [g] (Minimum Retraction Force) |
|---|---|---|---|---|
| GChi | 23.3 | −1.8 | 1.9 | −2.9 |
| GChiN1 N1 | 18.9 | −1.6 | 1.9 | −1.6 |
| GChiN2 | 19.1 | −1.4 | 1.9 | −1.4 |
Disclaimer/Publisher’s Note: The statements, opinions and data contained in all publications are solely those of the individual author(s) and contributor(s) and not of MDPI and/or the editor(s). MDPI and/or the editor(s) disclaim responsibility for any injury to people or property resulting from any ideas, methods, instructions or products referred to in the content. |
© 2023 by the authors. Licensee MDPI, Basel, Switzerland. This article is an open access article distributed under the terms and conditions of the Creative Commons Attribution (CC BY) license (https://creativecommons.org/licenses/by/4.0/).
Share and Cite
Lima, I.S.d.; Ferreira, M.O.G.; Barros, E.M.L.; Rizzo, M.d.S.; Santos, J.d.A.; Ribeiro, A.B.; Anteveli Osajima Furtini, J.; C. Silva-Filho, E.; Estevinho, L.M. Antibacterial and Healing Effect of Chicha Gum Hydrogel (Sterculia striata) with Nerolidol. Int. J. Mol. Sci. 2023, 24, 2210. https://doi.org/10.3390/ijms24032210
Lima ISd, Ferreira MOG, Barros EML, Rizzo MdS, Santos JdA, Ribeiro AB, Anteveli Osajima Furtini J, C. Silva-Filho E, Estevinho LM. Antibacterial and Healing Effect of Chicha Gum Hydrogel (Sterculia striata) with Nerolidol. International Journal of Molecular Sciences. 2023; 24(3):2210. https://doi.org/10.3390/ijms24032210
Chicago/Turabian StyleLima, Idglan Sá de, Maria Onaira Gonçalves Ferreira, Esmeralda Maria Lustosa Barros, Marcia dos Santos Rizzo, Jailson de Araújo Santos, Alessandra Braga Ribeiro, Josy Anteveli Osajima Furtini, Edson C. Silva-Filho, and Leticia M. Estevinho. 2023. "Antibacterial and Healing Effect of Chicha Gum Hydrogel (Sterculia striata) with Nerolidol" International Journal of Molecular Sciences 24, no. 3: 2210. https://doi.org/10.3390/ijms24032210
APA StyleLima, I. S. d., Ferreira, M. O. G., Barros, E. M. L., Rizzo, M. d. S., Santos, J. d. A., Ribeiro, A. B., Anteveli Osajima Furtini, J., C. Silva-Filho, E., & Estevinho, L. M. (2023). Antibacterial and Healing Effect of Chicha Gum Hydrogel (Sterculia striata) with Nerolidol. International Journal of Molecular Sciences, 24(3), 2210. https://doi.org/10.3390/ijms24032210

